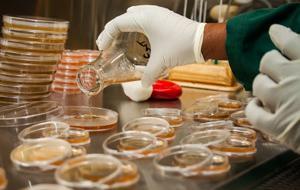
Environmental Testing & Analysis

Metal Testing Solution
Price:
Get Latest Price
Brand Name :
Monarch Biotech
In Stock
Product Specifications
| Product Type | Metal Testing |
| Dominant Color | Silver |
| Test Types | Tensile, Bend |
| Materials Tested | Metals |
| Accuracy | High |
| Measurement Units | MPa, mm |
| Standards Compliance | ASTM |
| Usage | Testing cables, fasteners, valves, bolts, and steel pipes |
| Features | Accurate testing, Expert guidance, High accuracy, Budget-friendly, Stress measurement, Strain measurement |
Company Details
MONARCH BIOTECH PRIVATE LIMITED is a well known Testing Lab established in the year 2005 and got itself engaged in Laboratory Testing Activities. Taking successive steps we acquired AERB, NABL accreditation followed by BIS recognition for Radiological testing in Packaged Drinking Water, Natural Mineral Water, Water Quality Testing, Food Matrices and Soils etc.Monarch Nuclear counting laboratory was the first radiological commercial testing lab in private sector from 2007.Gradually Monarch nuclear counting laboratory began to stake itself as the most competent, best equipped radio chemistr
Business Type
Service Provider
Employee Count
25
Establishment
2005
Working Days
Monday To Sunday
GST NO
33AAECM0612M1ZQ
More Product From This seller
Seller Details
GST - 33AAECM0612M1ZQ
Chennai, Tamil Nadu
Operation Manager
Mr. Prabhusankar Rajasekaran
Address
No. 37A, SIDCO Industrial Estate, Thirumazhisai, Chennai, Tamil Nadu, 600124, India
Analytical Testing Laboratories in Chennai
Report incorrect details